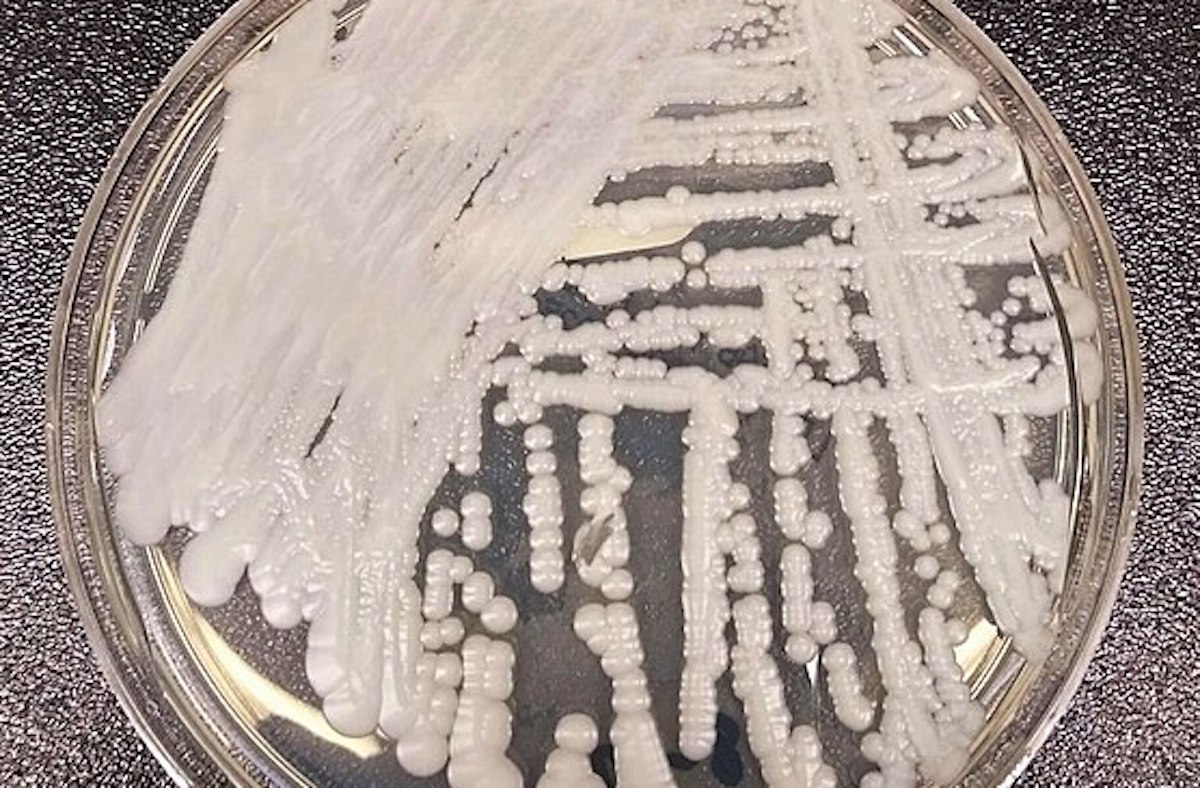

Кандида Грибы Форум

⚡ 👉🏻👉🏻👉🏻 ВСЯ ИНФОРМАЦИЯ ДОСТУПНА ЗДЕСЬ, КЛИКАЙ 👈🏻👈🏻👈🏻
Купить Равел СР в Рассказово
Купить Дицинон в Орехово-Зуево
Купить Красная щетка (родиола четырехчленная) в Билибине
Купить Фарингосепт в Оленегорске
Кандида Грибы Форум









1)/microscopic-image-of-thrush-infection-of-candidiasis-157144945-57a8b2443df78cf45918cb3f.jpg" width="550" alt="Кандида Грибы Форум" title="Кандида Грибы Форум">












_SEM.jpg" width="550" alt="Кандида Грибы Форум" title="Кандида Грибы Форум">